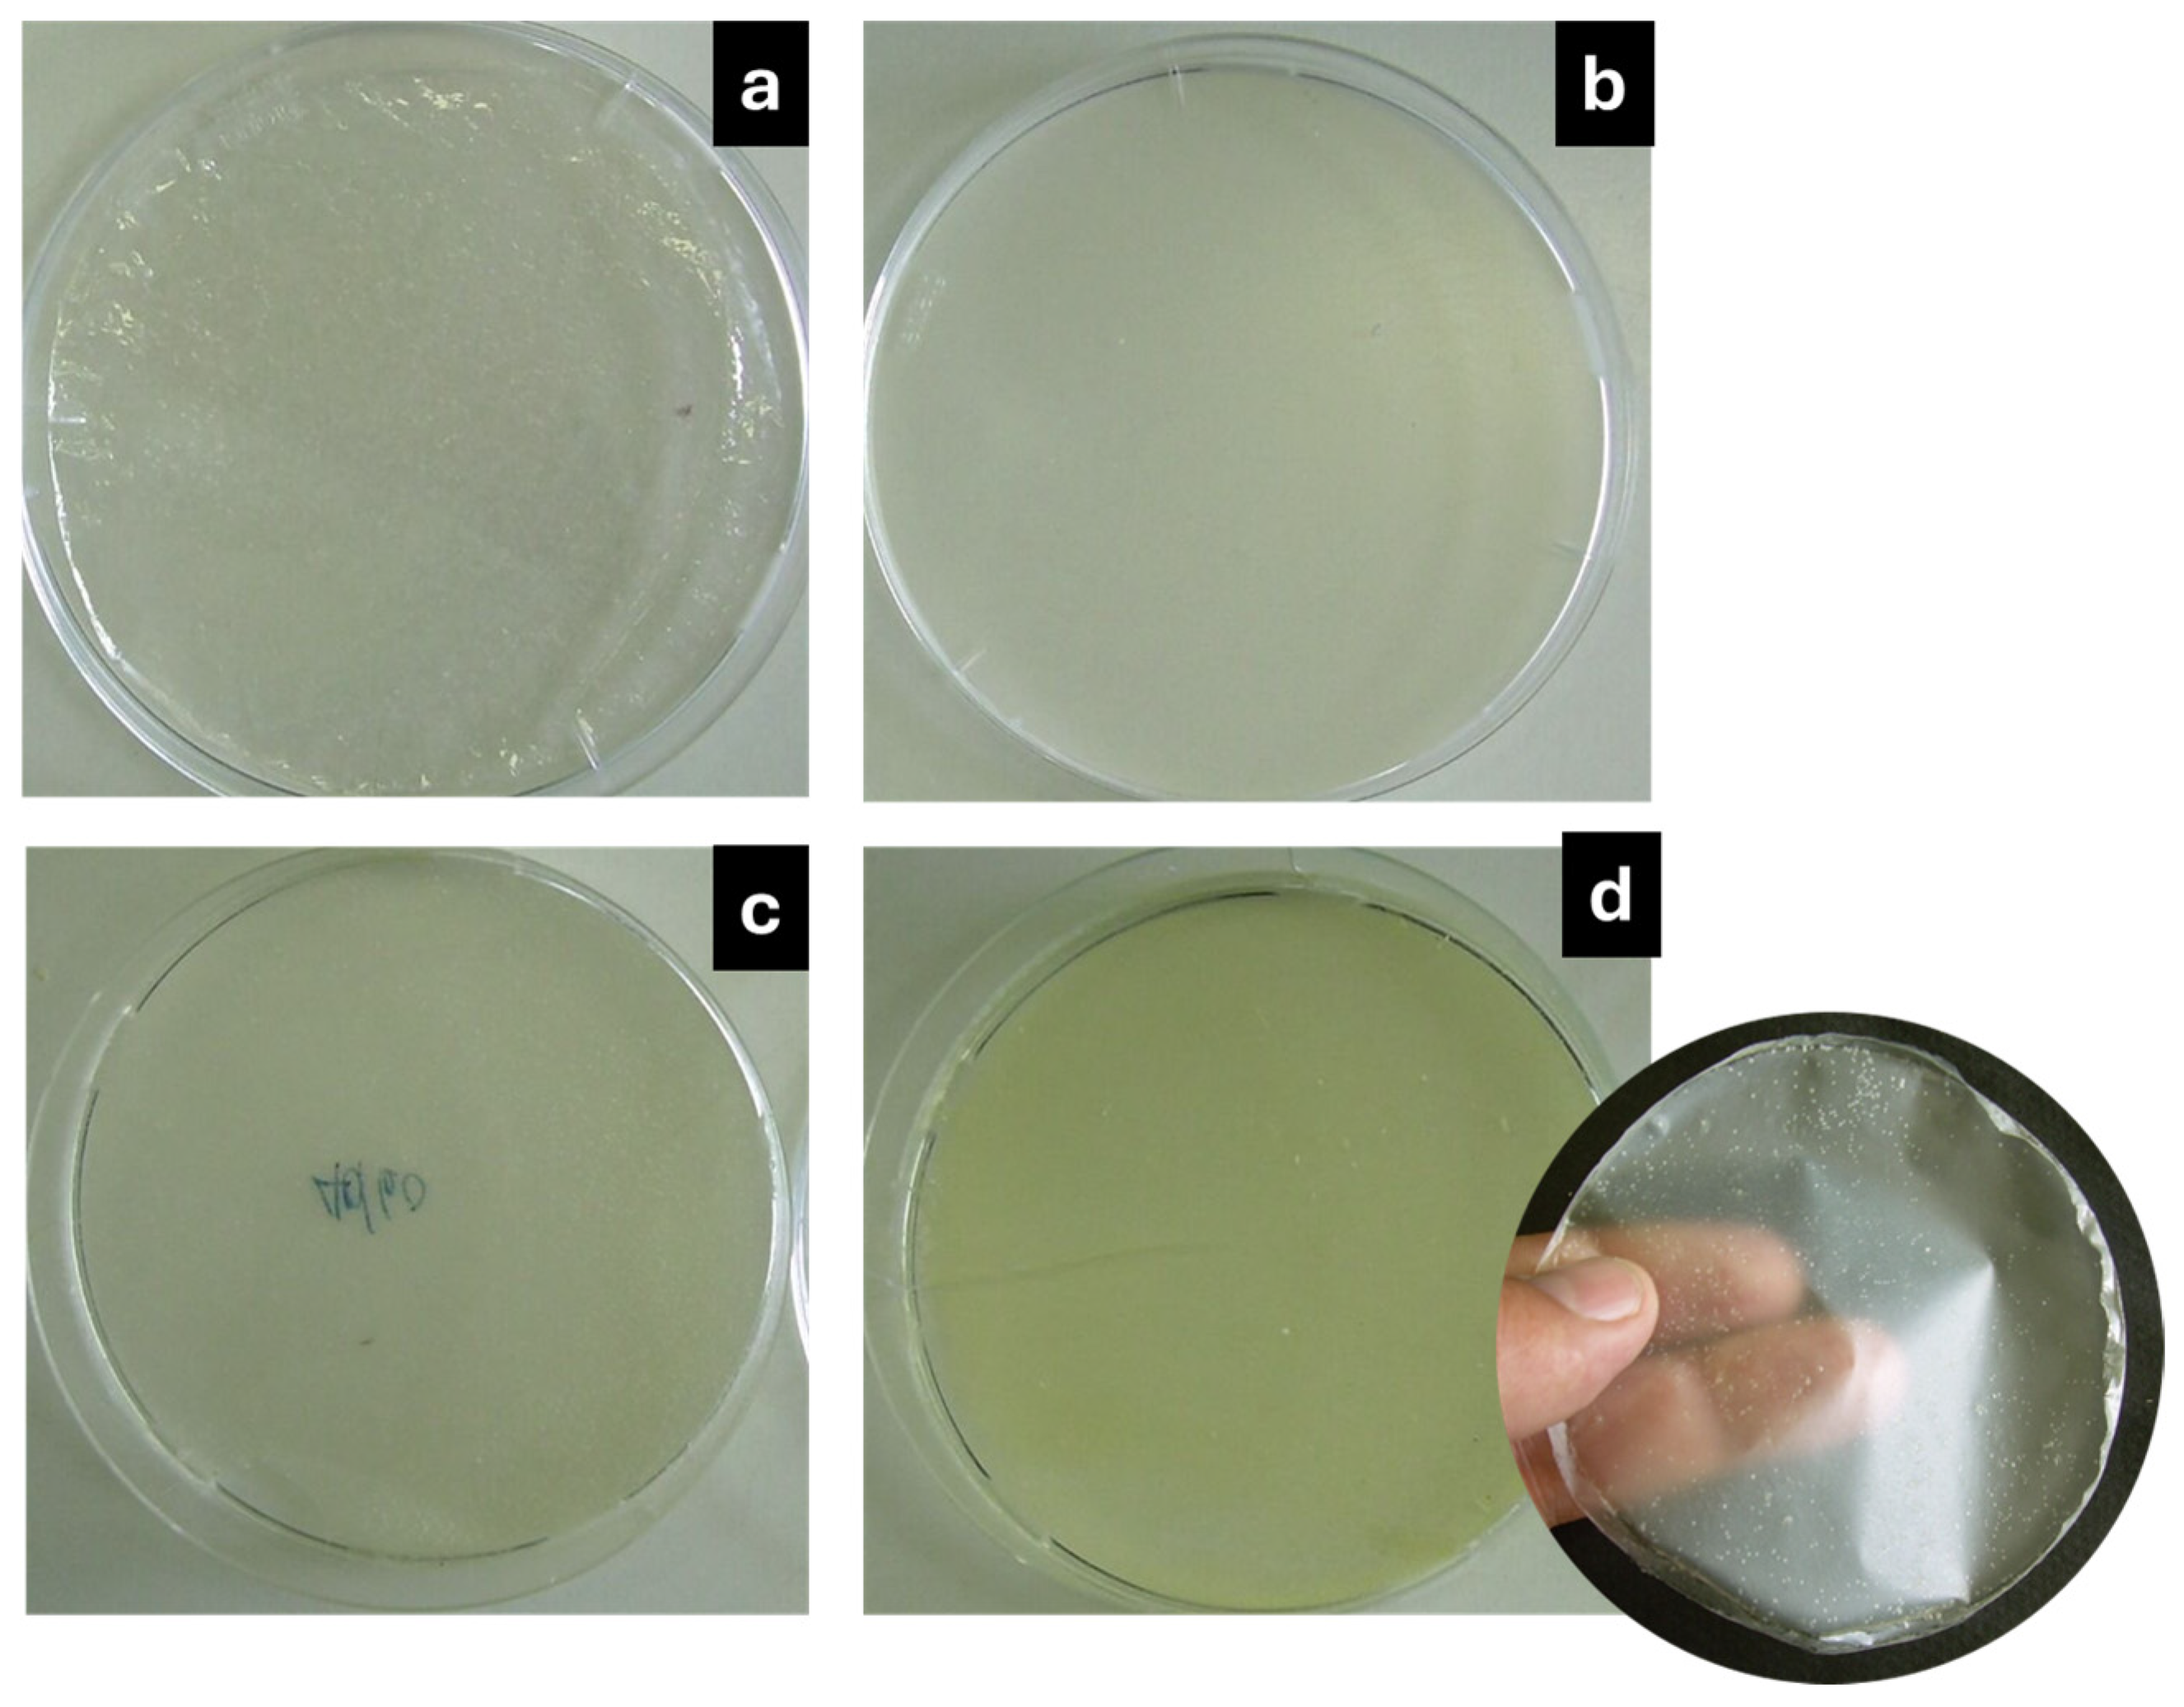
Foods 14 00256 g001
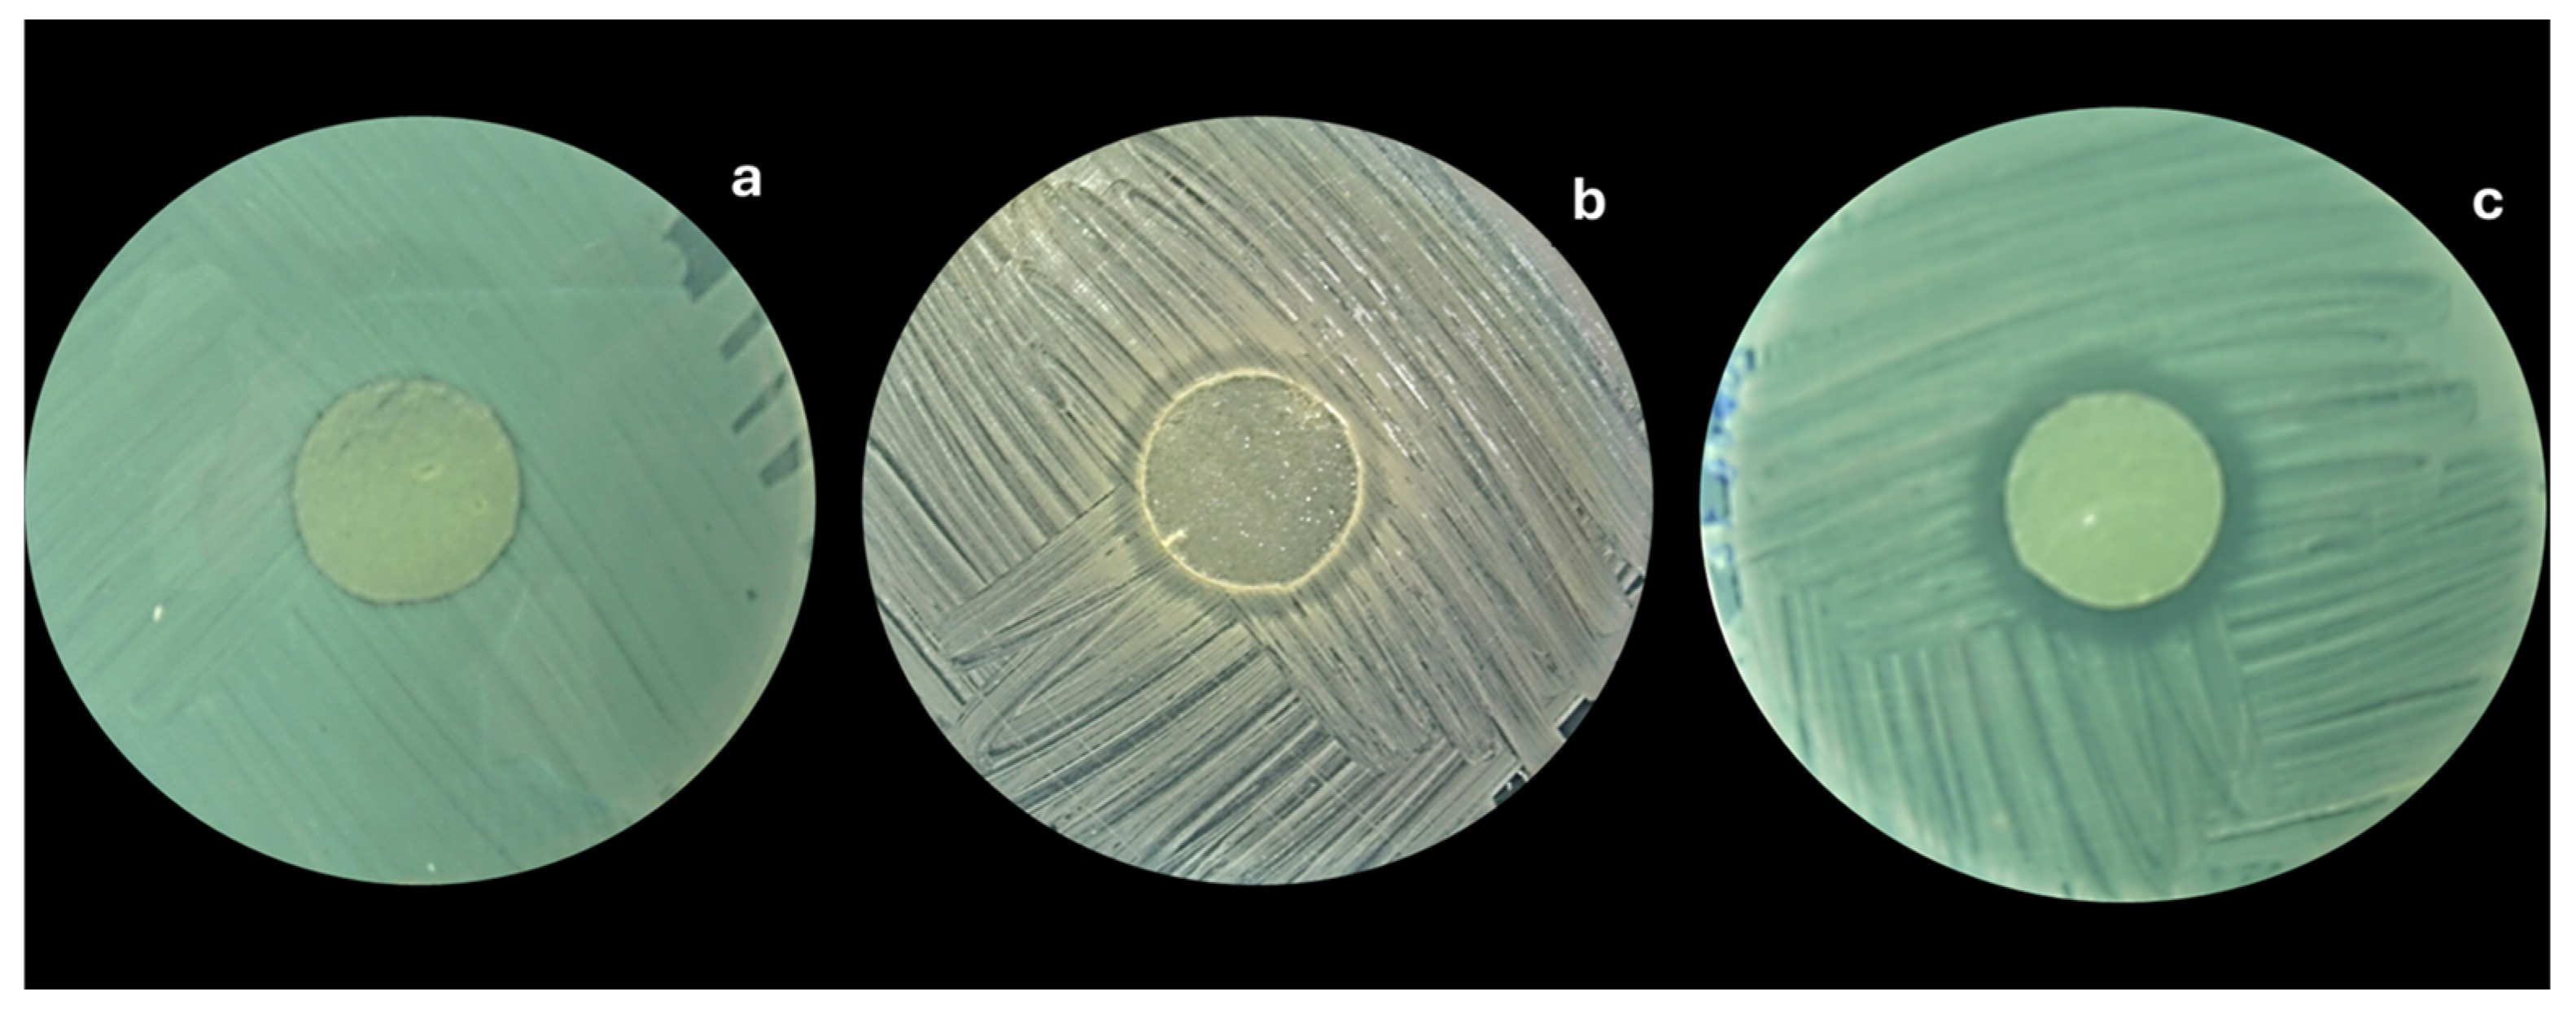
Foods 14 00256 g008

Development of Alginate-Chitosan Bioactive Films Containing Essential Oils for Use in Food Packaging
Abstract
:1. Introduction
2. Materials and Methods
2.1. Materials
2.2. Methods
2.2.1. Determination of Antibacterial Properties of Essential Oils
2.2.2. Preparation of Alginate-Chitosan Films
2.2.3. Preparation of Alginate-Chitosan Films with Antimicrobial Agents
2.2.4. Determination of Physical Properties (Methodology)
Film Thickness
Color, Yellowness Index, and Whiteness Index
Water Vapor Permeability (WVP)
2.2.5. Determination of Mechanical Properties
2.2.6. Scanning Electron Microscopy (SEM)
2.2.7. Thermogravimetry Analysis
2.2.8. FTIR
2.2.9. Antibacterial Effect of the Alginate-Chitosan Films
2.3. Statistical Analysis
3. Results and Discussion
3.1. Determination of the Minimum Inhibitory Concentration (MIC) and Minimum Bactericidal Concentration (MBC) of Essential Oils
3.2. Physical Properties
3.2.1. Film Thickness
3.2.2. Color Measurement, Yellowness Index (YI), and Whiteness Index (WI)
3.2.3. Water Vapor Permeability
3.2.4. Determination of Mechanical Properties (Tensile Strength and Elongation at Break)
3.2.5. Microstructural Features
3.2.6. Thermogravimetry Analysis
3.2.7. FTIR
3.2.8. Antibacterial Effect of Alginate-Chitosan Films
4. Conclusions
Author Contributions
Funding
Data Availability Statement
Acknowledgments
Conflicts of Interest
Correction Statement
References
- Wang, M.; Wei, Z.; Zhang, Z. Antimicrobial edible films for food preservation: Recent advances and future trends. Food Bioprocess Technol. 2024, 17, 1391–1411. [Google Scholar] [CrossRef]
- Shah, Y.A.; Bhatia, S.; Al-Harrasi, A.; Tarahi, M.; Almasi, H.; Chawla, R.; Ali, A.M. Insights into recent innovations in barrier resistance of edible films for food packaging applications. Int. J. Biol. Macromol. 2024, 271, 132354. [Google Scholar] [CrossRef] [PubMed]
- Olawade, D.B.; Wada, O.Z.; Ige, A.O. Advances and recent trends in plant-based materials and edible films: A mini-review. Front. Chem. 2024, 12, 1441650. [Google Scholar] [CrossRef] [PubMed]
- Chroho, M.; Youssef Rouphael, Y.; Petropoulos, S.A.; Bouissane, L. Carvacrol and Thymol Content Affects the Antioxidant and Antibacterial Activity of Origanum compactum and Thymus zygis Essential Oils. Antibiotics 2024, 13, 139. [Google Scholar] [CrossRef] [PubMed]
- Benlloch-Tinoco, M.; Gentile, P.; Taylor, L.; Girón-Hernández, J. Alginate edible films as delivery systems for green tea polyphenols. Food Hydrocoll. 2025, 158, 110518. [Google Scholar] [CrossRef]
- Edo, G.I.; Yousif, E.; Al-Mashhadani, M.H. Chitosan: An overview of biological activities, derivatives, properties, and current advancements in biomedical applications. Carbohydr. Res. 2024, 542, 109199. [Google Scholar] [CrossRef] [PubMed]
- Sinha, S. An overview of biopolymer-derived packaging material. Polym. Renew. Resour. 2024, 15, 193–209. [Google Scholar] [CrossRef]
- Moeini, A.; Germann, N.; Malinconico, M.; Santagata, G. Formulation of secondary compounds as additives of biopoly-mer-based food packaging: A review. Trends Food Sci. Technol. 2021, 114, 342–354. [Google Scholar] [CrossRef]
- Gan, H.; Lv, M.; Lv, C.; Fu, Y.; Ma, H. Inhibitory effect of chitosan-based coating on the deterioration of muscle quality of Pacific white shrimp at 4 °C storage. J. Food Process. Preserv. 2021, 45, e15167. [Google Scholar] [CrossRef]
- Benavides, S.; Cortés, P.; Parada, J.; Franco, W. Development of alginate microspheres containing thyme essential oil using ionic gelation. Food Chem. 2016, 204, 77–83. [Google Scholar] [CrossRef]
- Pan, J.; Li, Y.; Chen, K.; Zhang, Y.; Zhang, H. Enhanced physical and antimicrobial properties of alginate/chitosan composite aerogels based on electrostatic interactions and noncovalent crosslinking. Carbohydr. Polym. 2021, 266, 118102. [Google Scholar] [CrossRef]
- Karimi-Khorrami, N.; Radi, M.; Amiri, S.; Abedi, E.; McClements, D.J. Fabrication, characterization, and performance of antimicrobial alginate-based films containing thymol-loaded lipid nanoparticles: Comparison of nanoemulsions and nanostructured lipid carriers. Int. J. Biol. Macromol. 2022, 207, 801–812. [Google Scholar] [CrossRef] [PubMed]
- Yang, L.; Yang, Y.; Yang, Y.; He, K.; Jiang, G.; Tian, Y. Bioactive composite films with improved antioxidant and barrier properties prepared from sodium alginate and deep eutectic solvent treated distillers’ grains. Int. J. Biol. Macromol. 2024, 275, 133376. [Google Scholar] [CrossRef] [PubMed]
- Benavides, S.; Villalobos-Carvajal, R.; Reyes, J.E. Physical, mechanical and antibacterial properties of alginate film: Effect of the crosslinking degree and oregano essential oil concentration. J. Food Eng. 2012, 110, 232–239. [Google Scholar] [CrossRef]
- Sun, L.; Sun, J.; Chen, L.; Niu, P.; Yang, X.; Guo, Y. Preparation and characterization of chitosan film incorporated with thinned young apple polyphenols as an active packaging material. Carbohydr. Polym. 2017, 163, 81–91. [Google Scholar] [CrossRef]
- van den Broek, L.A.; Knoop, R.J.; Kappen, F.H.; Boeriu, C.G. Chitosan films and blends for packaging material. Carbohydr. Polym. 2015, 116, 237–242. [Google Scholar] [CrossRef] [PubMed]
- Cazón, P.; Vázquez, M. Mechanical and barrier properties of chitosan combined with other components as food packaging film. Environ. Chem. Lett. 2020, 18, 257–267. [Google Scholar] [CrossRef]
- Zhao, X.; Wang, X.; Lou, T. Preparation of fibrous chitosan/sodium alginate composite foams for the adsorption of cationic and anionic dyes. J. Hazard. Mater. 2021, 403, 124054. [Google Scholar] [CrossRef]
- Kulig, D.; Zimoch-Korzycka, A.; Jarmoluk, A.; Marycz, K. Study on alginate–chitosan complex formed with different polymers ratio. Polymers 2016, 8, 167. [Google Scholar] [CrossRef]
- Arzate-Vázquez, I.; Chanona-Pérez, J.J.; Calderón-Domínguez, G.; Terres-Rojas, E.; Garibay-Febles, V.; Martínez-Rivas, A.; Gutiérrez-López, G.F. Microstructural characterization of chitosan and alginate films by microscopy techniques and texture image analysis. Carbohydr. Polym. 2012, 87, 289–299. [Google Scholar] [CrossRef]
- Conzatti, G.; Faucon, D.; Castel, M.; Ayadi, F.; Cavalie, S.; Tourrette, A. Alginate/chitosan polyelectrolyte complexes: A comparative study of the influence of the drying step on physicochemical properties. Carbohydr. Polym. 2017, 72, 142–151. [Google Scholar] [CrossRef] [PubMed]
- Vergis, J.; Gokulakrishnan, P.; Agarwal, R.K.; Kumar, A. Essential oils as natural food antimicrobial agents: A review. Crit. Rev. Food Sci. Nutr. 2015, 55, 1320–1323. [Google Scholar] [CrossRef] [PubMed]
- Evangelopoulou, G.; Solomakos, N.; Ioannidis, A.; Pexara, A.; Burriel, A.R. A comparative study of the antimicrobial activity of oregano, rosemary and thyme essential oils against Salmonella spp. Biomed. Res. Clin. Pract. 2019, 4, 1–7. [Google Scholar] [CrossRef]
- Micić, D.; Đurović, S.; Riabov, P.; Tomić, A.; Šovljanski, O.; Filip, S.; Tosti, T.; Dojčinović, B.; Božović, R.; Jovanović, D.; et al. Rosemary Essential Oils as a Promising Source of Bioactive Compounds: Chemical Composition, Thermal Properties, Biological Activity, and Gastronomical Perspectives. Foods 2021, 10, 2734. [Google Scholar] [CrossRef] [PubMed]
- Yemiş, G.P.; Candoğan, K. Antibacterial activity of soy edible coatings incorporated with thyme and oregano essential oils on beef against pathogenic bacteria. Food Sci. Biotechnol. 2017, 26, 1113–1121. [Google Scholar] [CrossRef] [PubMed]
- Basavegowda, N.; Baek, K.H. Synergistic antioxidant and antibacterial advantages of essential oils for food packaging ap-plications. Biomolecules 2021, 11, 1267. [Google Scholar] [CrossRef] [PubMed]
- Ribeiro-Santos, R.; Andrade, M.; Sanches-Silva, A. Application of encapsulated essential oils as antimicrobial agents in food packaging. Curr. Opin. Food Sci. 2017, 14, 78–84. [Google Scholar] [CrossRef]
- Kim, J.H.; Lee, E.S.; Song, K.J.; Kim, B.M.; Ham, J.S.; Oh, M.H. Development of Desiccation-Tolerant Probiotic Biofilms Inhi-bitory for Growth of Foodborne Pathogens on Stainless Steel Surfaces. Foods 2022, 11, 831. [Google Scholar] [CrossRef]
- Chawla, R.; Sivakumar, S.; Kaur, H. Antimicrobial edible films in food packaging: Current scenario and recent nanotech-nological advancements—A review. Carbohydr. Polym. Technol. Appl. 2021, 2, 100024. [Google Scholar] [CrossRef]
- Benavides, S.; Mariotti-Celis, M.S.; Paredes, M.J.C.; Parada, J.A.; Franco, W.V. Thyme essential oil loaded microspheres for fish fungal infection: Microstructure in vitro dynamic release antifungal activity. J. Microencapsul. 2021, 38, 11–21. [Google Scholar] [CrossRef]
- Ghosh, V.; Ranjha, R.; Gupta, A.K. Polymeric encapsulation of anti-larval essential oil nanoemulsion for controlled release of bioactive compounds. Inorg. Chem. Commun. 2023, 150, 110507. [Google Scholar] [CrossRef]
- Tong, W.Y.; Ahmad Rafiee, A.R.; Leong, C.R.; Tan, W.N.; Dailin, D.J.; Almarhoon, Z.M.; Shelkh, M.; Nawaz, A.; Chuah, L.F. Development of sodium alginate-pectin biodegradable active food packaging film containing cinnamic acid. Chemosphere 2023, 336, 139212. [Google Scholar] [CrossRef] [PubMed]
- Zhou, Y.; Wu, X.; Chen, J.; He, J. Effects of cinnamon essential oil on the physical, mechanical, structural and thermal properties of cassava starch-based edible films. Int. J. Biol. Macromol. 2021, 184, 574–583. [Google Scholar] [CrossRef] [PubMed]
- Sharma, S.; Barkauskaite, S.; Jaiswal, A.K.; Jaiswal, S. Essential oils as additives in active food packaging. Food Chem. 2021, 343, 128403. [Google Scholar] [CrossRef]
- Hajibonabi, A.; Yekani, M.; Sharifi, S.; Sadri Nahad, J.; Maleki Dizaj, S.; Yousef Memar, M. Antimicrobial activity of nano-formulations of carvacrol and thymol: New trend and applications. OpenNano 2023, 13, 100170. [Google Scholar] [CrossRef]
- Li, Y.-X.; Erhunmwunsee, F.; Liu, M.; Yang, K.; Zheng, W.; Tian, J. Antimicrobial mechanisms of spice essential oils and application in food industry. Food Chem. 2022, 382, 132312. [Google Scholar] [CrossRef]
- Shen, Q.-J.; Sun, J.; Pan, J.-N.; Yu, T.; Zhou, W.-W. Synergistic antimicrobial potential of essential oil nanoemulsion and ultrasound and application in food industry: A review. Innov. Food Sci. Emerg. Technol. 2024, 98, 103867. [Google Scholar] [CrossRef]
- Casalino, G.; Dinardo, F.R.; D’Amico, F.; Bozzo, G.; Bove, A.; Camarda, A.; Circella, E. Antimicrobial efficacy of cinnamon essential oil against Avian Pathogenic Escherichia coli from poultry. Animals 2023, 13, 2639. [Google Scholar] [CrossRef]
- Galgano, M.; Capozza, P.; Pellegrini, F.; Cordisco, M.; Sposato, A.; Sblano, S.; Pratelli, A. Antimicrobial activity of essential oils evaluated in vitro against Escherichia coli and Staphylococcus aureus. Antibiotics 2022, 11, 979. [Google Scholar] [CrossRef] [PubMed]
- Ersanli, C.; Tzora, A.; Skoufos, I.; Fotou, K.; Maloupa, E.; Grigoriadou, K.; Zeugolis, D.I. The assessment of antimicrobial and anti-biofilm activity of essential oils against Staphylococcus aureus strains. Antibiotics 2023, 12, 384. [Google Scholar] [CrossRef]
- Morshdy, A.E.M.; El-Tahlawy, A.S.; Qari, S.H.; Qumsani, A.T.; Bay, D.H.; Sami, R.; Hussein, M.A. Anti-biofilms’ activity of garlic and thyme essential oils against Salmonella typhimurium. Molecules 2022, 27, 2182. [Google Scholar] [CrossRef] [PubMed]
- Meenu, M.; Padhan, B.; Patel, M.; Patel, R.; Xu, B. Antibacterial activity of essential oils from different parts of plants against Salmonella and Listeria spp. Food Chem. 2023, 404, 134723. [Google Scholar] [CrossRef]
- Campana, R.; Tiboni, M.; Maggi, F.; Cappellacci, L.; Cianfaglione, K.; Morshedloo, M.R.; Casettari, L. Comparative analysis of the antimicrobial activity of essential oils and their formulated microemulsions against foodborne pathogens and spoilage bacteria. Antibiotics 2022, 11, 447. [Google Scholar] [CrossRef]
- Kernou, O.N.; Azzouz, Z.; Madani, K.; Rijo, P. Application of rosmarinic acid with its derivatives in the treatment of microbial pathogens. Molecules 2023, 28, 4243. [Google Scholar] [CrossRef]
- Kowalewska, A.; Majewska-Smolarek, K. Eugenol-based polymeric materials—Antibacterial activity and applications. Antibiotics 2023, 12, 1570. [Google Scholar] [CrossRef] [PubMed]
- Becheran-Maron, L.; Peniche, C.; Arguelles-Monal, W. Study of the inter-polyelectrolyte reaction between chitosan and alginate: Influence of alginate composition and chitosan molecular weight. Int. J. Biol. Macromol. 2004, 34, 127–133. [Google Scholar] [CrossRef] [PubMed]
- Wang, S.; Ren, Z.; Li, H.; Xue, Y.; Zhang, M.; Li, R.; Liu, P. Preparation and sustained-release of chitosan-alginate bilayer microcapsules containing aromatic compounds with different functional groups. Int. J. Biol. Macromol. 2024, 271, 132663. [Google Scholar] [CrossRef] [PubMed]
- Kiehlbauch, J.A.; Hannett, G.E.; Salfinger, M.; Archinal, W.; Monserrat, C.; Carlyn, C. Use of the National Committee for Clinical Laboratory Standards guidelines for disk diffusion susceptibility testing in New York State Laboratories. J. Clin. Microbiol. 2000, 38, 3341–3348. [Google Scholar] [CrossRef] [PubMed]
- Łopusiewicz, Ł.; Drozlowska, E.; Trocer, P.; Kostek, M.; Śliwiński, M.; Henriques, M.H.F.; Bartkowiak, A.; Sobolewski, P. Whey protein concentrate/isolate biofunctional films modified with melanin from watermelon (Citrullus lanatus) seeds. Materials 2020, 13, 3876. [Google Scholar] [CrossRef]
- Mchugh, H.; Bustillos, A.; Krochta, J. Hydrophilic Edible Films: Modified Procedure for Water Vapor Permeability and Explanation of Thickness Effects. J. Food Sci. 1993, 58, 899–903. [Google Scholar] [CrossRef]
- He, J.; Zhang, W.; Goksen, G.; Khan, M.R.; Ahmad, N.; Cong, X. Functionalized sodium alginate composite films based on double-encapsulated essential oil of wampee nanoparticles: A green preservation material. Food Chem. 2024, 24, 101842. [Google Scholar] [CrossRef] [PubMed]
- Chen, M.H.; Yeh, G.H.; Chiang, B.H. Antimicrobial and physicochemical properties of methylcellulose and chitosan films containing a preservative. J. Food Process. Preserv. 1996, 20, 379–390. [Google Scholar] [CrossRef]
- Timoracká, I.; Kunová, S.; Lovászová, V.Z.; Demianová, A.; Poláková, K.; Korčok, M.; Kačániová, M. Microbiological quality assessment of rainbow trout Oncorhyncus mykiss) meat treated with rosemery an thyme dried herbs and essential oils. J. Mi-crobiol. Biotechnol. Food Sci. 2024, 14, e11157. [Google Scholar] [CrossRef]
- Fakhouri, F.M.; Martelli, S.M.; Caon, T.; Velasco, J.I.; Buontempo, R.C.; Bilck, A.P.; Innocentini Mei, L.H. The effect of fatty acids on the physicochemical properties of edible films composed of gelatin and gluten proteins. LWT Food Sci. Technol. 2018, 87, 293–300. [Google Scholar] [CrossRef]
- Vieira, T.M.; Moldão-Martins, M.; Alves, V.D. Design of chitosan and alginate emulsion-based formulations for the production of monolayer crosslinked edible films and coatings. Foods 2021, 10, 1654. [Google Scholar] [CrossRef] [PubMed]
- Perumal, A.B.; Huang, L.; Nambiar, R.B.; He, Y.; Li, X.; Sellamuthu, P.S. Application of essential oils in packaging films for the preservation of fruits and vegetables: A review. Food Chem. 2022, 375, 131810. [Google Scholar] [CrossRef]
- Cofelice, M.; Cuomo, F.; Chiralt, A. Alginate films encapsulating lemongrass essential oil as affected by spray calcium application. Colloids Interfaces 2019, 3, 58. [Google Scholar] [CrossRef]
- Cabrera-Barjas, G.; Jimenez, R.; Romero, R.; Valdes, O.; Nesic, A.; Hernández-García, R.; Neira, A.; Alejandro-Martín, S.; de la Torre, A.F. Value-added long-chain aliphatic compounds obtained through pyrolysis of phosphorylated chitin. Int. J. Biol. Macromol. 2023, 238, 124130. [Google Scholar] [CrossRef] [PubMed]
- Cárdenas, G.; Paredes, J.C.; Cabrera, G.; Casals, P. Synthesis and characterization of chitosan alkyl carbamates. J. Appl. Polym. Sci. 2002, 86, 2742–2747. [Google Scholar] [CrossRef]
- Popa, R.M.; Fetea, F.; Socaciu, C. ATR-FTIR-MIR Spectrometry and Pattern Recognition of Bioactive Volatiles in Oily versus Microencapsulated Food Supplements: Authenticity, Quality, and Stability. Molecules 2021, 26, 4837. [Google Scholar] [CrossRef]
- Pandey, S.; Sekar, H.; Gundabala, V. Development and characterization of bilayer chitosan/alginate cling film reinforced with essential oil-based nanocomposite for red meat preservation. Int. J. Biol. Macromol. 2024, 279, 135524. [Google Scholar] [CrossRef] [PubMed]
- Fiallos-Núñez, J.; Cardero, Y.; Cabrera-Barjas, G.; García-Herrera, C.M.; Inostroza, M.; Estevez, M.; Valenzuela, L.M. Eco-friendly design of chitosan-based films with biodegradable properties as an alternative to low-density polyethylene packaging. Polymers 2024, 16, 2471. [Google Scholar] [CrossRef]
- Berechet, M.D.; Gaidau, C.; Miletic, A.; Pilic, B.; Râpă, M.; Stanca, M.; Lazea-Stoyanova, A. Bioactive properties of nanofibres based on concentrated collagen hydrolysate loaded with thyme and oregano essential oils. Materials 2020, 13, 1618. [Google Scholar] [CrossRef] [PubMed]
- Radev, R.S.; Dimitrov, G.A. Water vapor permeability of edible films with different composition. Sci. Work. Univ. Food Technol. 2017, 64, 96–102. Available online: https://uft-plovdiv.bg/site_files/file/scienwork/scienworks_2017/docs/2-15.pdf (accessed on 1 November 2024).
- Agatonovic-Kustrin, S.; Ristivojevic, P.; Gegechkori, V.; Litvinova, T.M.; Morton, D.W. Essential oil quality and purity evaluation via FTIR spectroscopy and pattern recognition techniques. Appl. Sci. 2020, 10, 7294. [Google Scholar] [CrossRef]

| Strains | Antibacterial Parameter | |||
|---|---|---|---|---|
| MIC (mg/mL) | MBC (mg/mL) | |||
| EOT | EOO | EOT | EOO | |
| E. coli. | 1.39 ± 0.03 aA | 0.69 ± 0.03 bA | 2.78 ± 0.04 aA | 2.78 ± 0.04 aA |
| S. enterica | 1.39 ± 0.03 aA | 0.69 ± 0.03 bA | 5.56 ± 0.04 aB | 2.78 ± 0.04 bA |
| S. aureus | 0.69 ± 0.03 aB | 0.35 ± 0.03 bB | 2.78 ± 0.04 aA | 1.39 ± 0.04 bB |
| L. monocytogenes | 0.35 ± 0.03 aC | 0.17 ± 0.03 bC | 2.78 ± 0.04 aA | 1.39 ± 0.04 bB |
| Essential Oil Type | %EO | Thickness (µm) | Color (CIELAB Space) | WVP (g/msPa) × 10−9 | |||||
|---|---|---|---|---|---|---|---|---|---|
| L* | a* | b* | ΔE | YI | WI | ||||
| Control | 0.0 | 34.9 ± 3.7 a | 98.5 ± 0.17 a | −1.5 ± 0.18 a | 5.5 ± 0.18 a | 4.26 ± 0.21 a | 7.94 ± 0.27 a | 94.12 ± 0.20 a | 4.03 + 0.47 a |
| EOO | 1.0 | 38.2 ± 0.7 a | 88.3 ± 0.20 b | −3.5 ± 0.22 b | 11.7 ± 0.16 b | 12.1 ± 0.11 b | 18.9 ± 0.23 b | 83.1 ± 0.10 b | 3.19 + 0.15 b |
| 2.0 | 37.7 ± 1.2 a | 87.2 ± 0.47 c | −3.6 ± 0.08 b | 11.6 ± 0.13 b | 13.0 ± 0.37 c | 19.1 ± 0.18 b | 82.4 ± 0.29 c | 2.47 + 1.00 b | |
| 3.0 | 37.9 ± 0.9 a | 86.4 ± 0.09 c | −3.5 ± 0.15 b | 11.6 ± 0.07 b | 13.6 ± 0.06 c | 19.2 ± 0.11 b | 81.8 ± 0.05 c | 1.80 + 0.39 c | |
| EOT | 1.0 | 37.8 ± 0.5 a | 87.8 ± 0.10 b | -3.3 + 0.14 b | 11.5 ± 0.07 b | 12.3 ± 0.06 b | 18.7 ± 0.11 b | 82.9 ± 0.04 b | 3.04 ± 0.35 b |
| 2.0 | 38.2 ± 0.8 a | 86.8 ± 0.04 c | −3.7 ± 0.03 c | 11.6 ± 0.03 b | 13.3 ± 0.04 c | 19.1 ± 0.05 c | 82.0 ± 0.04 c | 2.45 ± 0.16 b | |
| 3.0 | 38.0 ± 0.5 a | 86.3 ± 0.03 d | −3.4 ± 0.02 b | 12.0 ± 0.14 c | 13.9 ± 0.05 d | 19.7 ± 0.22 d | 81.5 ± 0.07 d | 1.65 ± 0.69 c | |
| Sample | Temperature (°C) | Weight Loss (%) | ||
|---|---|---|---|---|
| Onset | Peak | End | ||
| Chitosan (CHI) | 24 | 66 | 135 | 3.8 |
| 251 | 310 | 402 | 50.4 | |
| Alginate (ALG) | 25 | 69 | 185 | 10.6 |
| 191 | 244 | 266 | 24.0 | |
| 266 | 284 | 319 | 10.9 | |
| 319 | 399 | 544 | 11.0 | |
| CHI-ALG | 30 | 87 | 133 | 10.1 |
| 134 | 216 | 234 | 24.6 | |
| 235 | 265 | 385 | 42.4 | |
| EOT 1% | 24 | 90 | 156 | 6.4 |
| 179 | 220 | 235 | 12.9 | |
| 236 | 260 | 360 | 34.9 | |
| 361 | 400 | 442 | 14.7 | |
| 443 | 477 | 525 | 4.2 | |
| EOT 2% | 26 | 73 | 157 | 5.9 |
| 195 | 225 | 239 | 11.1 | |
| 240 | 274 | 351 | 37.0 | |
| 352 | 399 | 443 | 18.8 | |
| 444 | 476 | 523 | 4.0 | |
| EOT 3% | 28 | 102 | 156 | 5.9 |
| 204 | 223 | 240 | 11.4 | |
| 241 | 267 | 352 | 41.3 | |
| 353 | 399 | 443 | 27.5 | |
| 444 | 477 | 524 | 3.6 | |
| EOO 1% | 24 | 81 | 149 | 7.0 |
| 205 | 219 | 235 | 10 | |
| 236 | 261 | 355 | 32.2 | |
| 356 | 396 | 438 | 15.5 | |
| 439 | 476 | 523 | 4.2 | |
| EOO 2% | 24 | 70 | 145 | 9.2 |
| 205 | 224 | 239 | 12.0 | |
| 240 | 273 | 353 | 32.0 | |
| 354 | 399 | 438 | 19.2 | |
| 439 | 476 | 523 | 4.0 | |
| EOO 3% | 26 | 83 | 149 | 6.8 |
| 204 | 221 | 241 | 18.3 | |
| 242 | 273 | 353 | 30.9 | |
| 354 | 400 | 438 | 26.8 | |
| 439 | 476 | 522 | 3.8 | |
| Concentration (%) | Inhibition Zone by Type of Essential Oil (Diameter in mm) | |||||||
|---|---|---|---|---|---|---|---|---|
| E. coli | S. enterica | S. aureus | L. monocytogenes | |||||
| EOO | EOT | EOO | EOT | EOO | EOT | EOO | EOT | |
| 0.0 | 0 Aa | 0 Aa | 0 Aa | 0 Aa | 0 Aa | 0 Aa | 0 Aa | 0 Aa |
| 1.0 | 26 ± 1.2 Ba | 30 ± 0.9 Bb | 22 ± 0.2 Ba | 26 ± 0.8 Ba | 24 ± 1.4 Ba | 27 ± 0.09 Ba | 27 ± 1.8 Ba | 40 ± 0.9 Bc |
| 2.0 | 25 ± 0.9 Ba | 39 ± 1.5 Cb | 28 ± 1.6 Ca | 28 ± 2.1 Ba | 30 ± 0.1 Ca | 38 ± 0.13 Cb | 37 ± 1.3 Cb | 46 ± 1.5 Cc |
| 3.0 | 39 ± 1.3 Ca | 41 ± 1.3 Ca | 35 ± 0.8 Da | 36 ± 0.9 Ca | 43 ± 1.2 Da | 49 ± 0.09 Db | 49 ± 1.3 Db | 55 ± 1.3 Db |
Disclaimer/Publisher’s Note: The statements, opinions and data contained in all publications are solely those of the individual author(s) and contributor(s) and not of MDPI and/or the editor(s). MDPI and/or the editor(s) disclaim responsibility for any injury to people or property resulting from any ideas, methods, instructions or products referred to in the content. |
© 2025 by the authors. Licensee MDPI, Basel, Switzerland. This article is an open access article distributed under the terms and conditions of the Creative Commons Attribution (CC BY) license (https://creativecommons.org/licenses/by/4.0/).
Share and Cite
Guzmán-Pincheira, C.; Moeini, A.; Oliveira, P.E.; Abril, D.; Paredes-Padilla, Y.A.; Benavides-Valenzuela, S. Development of Alginate-Chitosan Bioactive Films Containing Essential Oils for Use in Food Packaging. Foods 2025, 14, 256. https://doi.org/10.3390/foods14020256
Guzmán-Pincheira C, Moeini A, Oliveira PE, Abril D, Paredes-Padilla YA, Benavides-Valenzuela S. Development of Alginate-Chitosan Bioactive Films Containing Essential Oils for Use in Food Packaging. Foods. 2025; 14(2):256. https://doi.org/10.3390/foods14020256
Chicago/Turabian StyleGuzmán-Pincheira, Carla, Arash Moeini, Patricia E. Oliveira, Diana Abril, Yeni A. Paredes-Padilla, and Sergio Benavides-Valenzuela. 2025. "Development of Alginate-Chitosan Bioactive Films Containing Essential Oils for Use in Food Packaging" Foods 14, no. 2: 256. https://doi.org/10.3390/foods14020256
APA StyleGuzmán-Pincheira, C., Moeini, A., Oliveira, P. E., Abril, D., Paredes-Padilla, Y. A., & Benavides-Valenzuela, S. (2025). Development of Alginate-Chitosan Bioactive Films Containing Essential Oils for Use in Food Packaging. Foods, 14(2), 256. https://doi.org/10.3390/foods14020256








